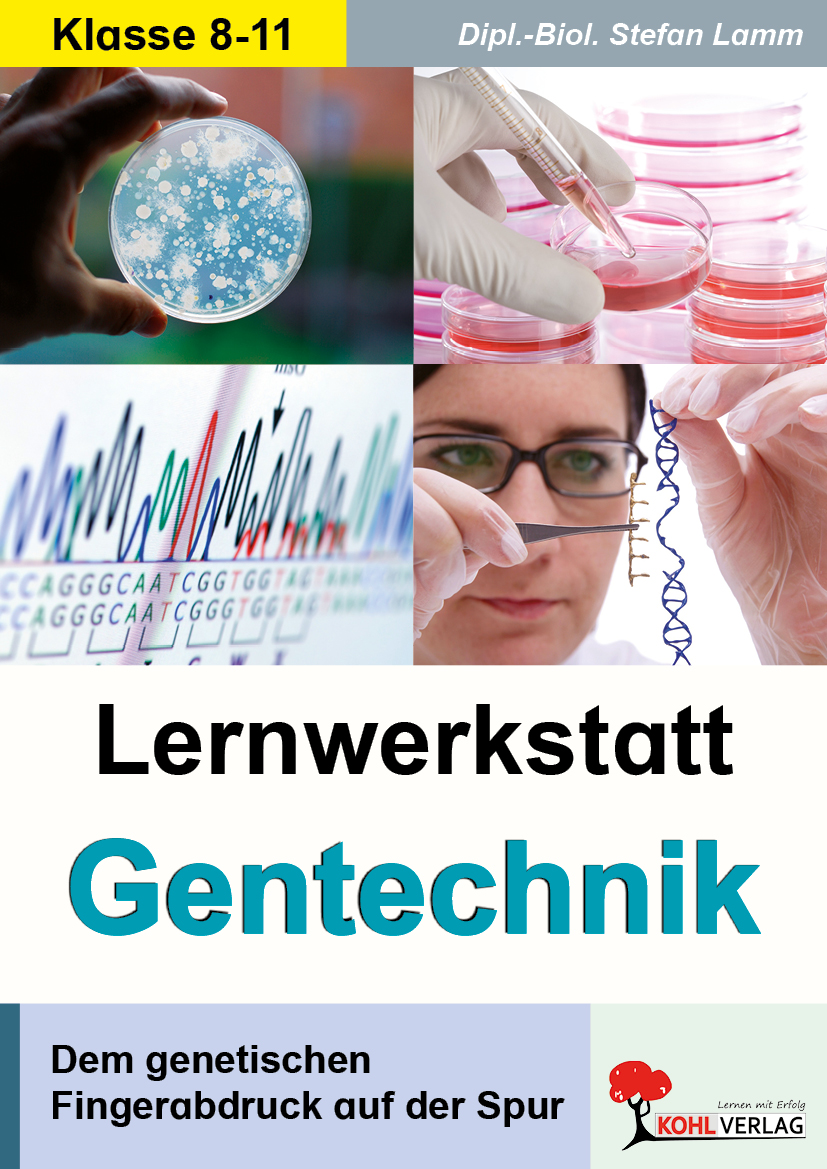

Lernwerkstatt Fahrradprüfung
Wie bewegst du dich sicher im Straßenverkehr?
Vermittelt alle wichtigen Grundlagen zur sicheren Teilnahme am Straßenverkehr.
Bereitet praxisnah und kindgerecht auf die Fahrradprüfung vor.
Fördert richtiges Verhalten, Aufmerksamkeit und Verantwortungsbewusstsein im Verkehr.
Eigenschaften
| Seitenanzahl: | 60 |
|---|---|
| Ausstattung: | Paperback, schwarz-weiß |
| Altersstufe: | Klasse 3, Klasse 4 |
| Schulform: | Grundschule |
| Fächer: | Sachunterricht |
| Methoden: | Grundschrift, Schriftart wählbar |
| Schwerpunkt: | Alltagskompetenz |
| Themen: | Fahrradprüfung, Verkehrserziehung |
Das Arbeitsheft ist vorgesehen zum Einsatz in der Grundschule in den Klassen 3 und 4. Die Arbeitsblätter enthalten zahlreiche Infotexte sowie zahlreiche Aufgaben hierzu zur Reflexion und Vertiefung des Gelesenen. Die Kopiervorlagen sind bestens geeignet zum selbstständigen Arbeiten und mit Lösungen - auch zur Selbstkontrolle - ausgestattet.
Die Fahrradprüfung bildet den Abschluss der Verkehrserziehung in der Grundschule. Hier wird der richtige Umgang im Straßenverkehr und die sichere Handhabung des Fahrrads geprüft. Der vorliegende Band beinhaltet wichtige Grundlagen rund um das Verhalten in verschiedenen Verkehrssituationen. Die Kinder lernen typische Straßenelemente kennen, wie Verkehrs- und Straßenschilder, Ampeln, Straßenkreuzungen, Kreisverkehre uvm. Die anschaulichen Verkehrsbeispiele fordern auf, sich mit diesen Elementen auseinanderzusetzen und das Erlernte bereits in der Theorie zu festigen. Der Band soll begleiten und eine erfolgreiche Fahrradprüfung sowie ein anschließend sicheres Verhalten im Verkehr erzielen.
Inhalt:
- Ich lerne mein Fahrrad kennen
- Das muss mein Fahrrad haben
- Da fehlt doch was …
- Hier stimmt etwas nicht
- Was noch wichtig ist
- Bremsen und Beleuchtung
- Der Helm
- Der Fahrradcheck
- Richtiges Verhalten
- Richtig Fahrrad fahren
- Darfst du das?
- Vorsicht
- Rücksicht
- Verkehrszeichen
- Rechts und links
- Verkehrszeichen, die Radfahrer kennen sollten
- Verkehrsschilder, die die Vorfahrt regeln
- Was stimmt denn nun?
- Würfelspiel zu den Verkehrszeichen
- Sudoku Verkehrszeichen
- Ampel, Zebrastreifen und Kreisverkehr
- An der Ampel
- Rot heißt stehen, grün heißt gehen
- Ampelrätsel
- Am Zebrastreifen
- Der Kreisverkehr
- Richtig abbiegen
- Der Start – Links abbiegen (Lückentext)
- Links abbiegen
- Möglichkeiten
- Rechts und links abbiegen
- Wer hat Vorfahrt?
- Die abknickende Vorfahrtsstraße
- Wer muss Handzeichen geben?
- Rechts vor links
- Wer ist der Erste? – Übungen
- Der tote Winkel
- Wie verhältst du dich richtig?
- Fahrradtraining auf dem Schulhof
- Bremsen und Schneckenrennen
- Spur halten
- Einhändig fahren, Seitenblick und Ampelspiele
- Checkliste – sicher Fahrrad fahren
- Verschiedene Aufgaben
- Welche Fehler machen die Radfahrer?
- Erste Hilfe auf dem Radweg
- Wartung und Pflege
- Lotta putzt ihr Fahrrad
- Bildergeschichte schreiben
- In der Stadt – Weg finden
- Aufgabe an deine Klasse
- Probe-Prüfungsbogen
- Übersicht über die wichtigsten Verkehrszeichen
Mit Lösungen - auch zur Selbstkontrolle.
| Print-Version | PDF-Einzellizenz | PDF-Schullizenz | Bundle Print & PDF-Einzellizenz | Bundle Print & PDF-Schullizenz | |
|---|---|---|---|---|---|
| Unbefristete Nutzung der Materialien | |||||
| Vervielfältigung, Weitergabe und Einsatz der Materialien im eigenen Unterricht | |||||
| Nutzung der Materialien durch alle Lehrkräfte des Kollegiums an der lizenzierten Schule | |||||
| Einstellen des Materials im Intranet oder Schulserver der Institution |
| Print-Version | |
|---|---|
| Unbefristete Nutzung der Materialien | |
| Vervielfältigung, Weitergabe und Einsatz der Materialien im eigenen Unterricht | |
| Nutzung der Materialien durch alle Lehrkräfte des Kollegiums an der lizenzierten Schule | |
| Einstellen des Materials im Intranet oder Schulserver der Institution |
| PDF-Einzellizenz | |
|---|---|
| Unbefristete Nutzung der Materialien | |
| Vervielfältigung, Weitergabe und Einsatz der Materialien im eigenen Unterricht | |
| Nutzung der Materialien durch alle Lehrkräfte des Kollegiums an der lizenzierten Schule | |
| Einstellen des Materials im Intranet oder Schulserver der Institution |
| PDF-Schullizenz | |
|---|---|
| Unbefristete Nutzung der Materialien | |
| Vervielfältigung, Weitergabe und Einsatz der Materialien im eigenen Unterricht | |
| Nutzung der Materialien durch alle Lehrkräfte des Kollegiums an der lizenzierten Schule | |
| Einstellen des Materials im Intranet oder Schulserver der Institution |
| Bundle Print & PDF-Einzellizenz | |
|---|---|
| Unbefristete Nutzung der Materialien | |
| Vervielfältigung, Weitergabe und Einsatz der Materialien im eigenen Unterricht | |
| Nutzung der Materialien durch alle Lehrkräfte des Kollegiums an der lizenzierten Schule | |
| Einstellen des Materials im Intranet oder Schulserver der Institution |
| Bundle Print & PDF-Schullizenz | |
|---|---|
| Unbefristete Nutzung der Materialien | |
| Vervielfältigung, Weitergabe und Einsatz der Materialien im eigenen Unterricht | |
| Nutzung der Materialien durch alle Lehrkräfte des Kollegiums an der lizenzierten Schule | |
| Einstellen des Materials im Intranet oder Schulserver der Institution |
Bei diesem Produkt kann die Schriftart individuell nach Ihren Wünschen gewählt werden. Sie bekommen auf Bestellung das Produkt als digitale Schullizenz wenige Tage nach der Bestellung zugemailt, da das Produkt zuerst auf Ihre Wünsche angepasst und personalisiert wird.
Die Bestellung geben Sie bitte direkt per Mail an die Redaktion ab. Schreiben Sie einfach an redaktion@kohlverlag.de und teilen Sie uns das gewünschte Produkt sowie die gewünschte Schriftart mit. Wir prüfen jede Anfrage und erstellen ein individuelles Angebot für Sie.
Standardschulschriften sind:

Ihre Wunschschriftart ist nicht dabei? Schreiben Sie uns, welche Schrift Sie gerne hätten. Wir versuchen, Ihre Wünsche zu realisieren.
Förderbedarf:
Diese Arbeitsblätter richten sich sowohl an Schüler*innen, die zusätzliche Förderung benötigen, als auch an diejenigen Schülerinnen, die ihre Fertigkeiten durch zusätzliches Übungsmaterial stärken oder erweitern möchten.
Inklusion:
Dieses Arbeitsheft eignet sich zum Einsatz im inklusiven Unterricht sowie zur sonderpädagogischen Förderung.
Begabtenförderung:
Diese Arbeitsblätter sind besonders geeignet für starke Schüler*innen, bei denen zusätzliches Material zur Vertiefung und Erweiterung des Wissens sinnvoll ist.
Lernen an Stationen:
In diesem Arbeitsheft werden diverse Lernstationen zur individuellen Bearbeitung bereitgestellt. Diese eignen sich bestens zum selbstständigen Arbeiten in der Freiarbeit. Die Arbeitsblätter sind durchgehend dreifach differenziert (Basisniveau, Mittleres Niveau, Erweitertes Niveau).
Arbeitsmaterial zur Differenzierung:
Diese Arbeitsblätter sind durchgehend in drei Niveaustufen (Basisniveau, Mittleres Niveau, Erweitertes Niveau) eingeteilt. Somit lässt sich innerhalb der Klasse/Gruppe je nach Leistungsstärke differenzieren.
Zusatzmaterial:
Zu diesem Produkt steht weiteres Zusatz- und Ergänzungsmaterial zum Download bereit.
Interaktive Arbeitsblätter:
Dieses Arbeitsheft bietet interaktive Arbeitsblätter, die auf allen Endgeräten (Handy, Tablet, Laptop, PC) direkt digital bearbeitbar sind.
Fächerübergreifend einsetzbar:
Diese Arbeitsblätter können mit verschiedenen Fächern (z.B. Deutsch, Sachunterricht und Religion) fächerübergreifend verknüpft und eingesetzt werden.
Grundschrift:
Die Arbeitsblätter dieses Produktes sind zwecks besserer Lesbarkeit in der Schriftart "Grundschrift" gehalten.
Grundschrift mit Sprechsilbenfärbung:
Dieses Produkt ist zur einfachen Lesbarkeit in der Grundschrift mit Sprechsilbenfärbung angelegt. Die Schriftgröße und der Zeilenabstand sind größer.
18,80 € Nur 0,31 € pro Seite
Sofort verfügbar, Lieferzeit: 1-3 Tage
In Deutschland versandkostenfrei
60 Seiten
Klasse 3, Klasse 4
Sachunterricht